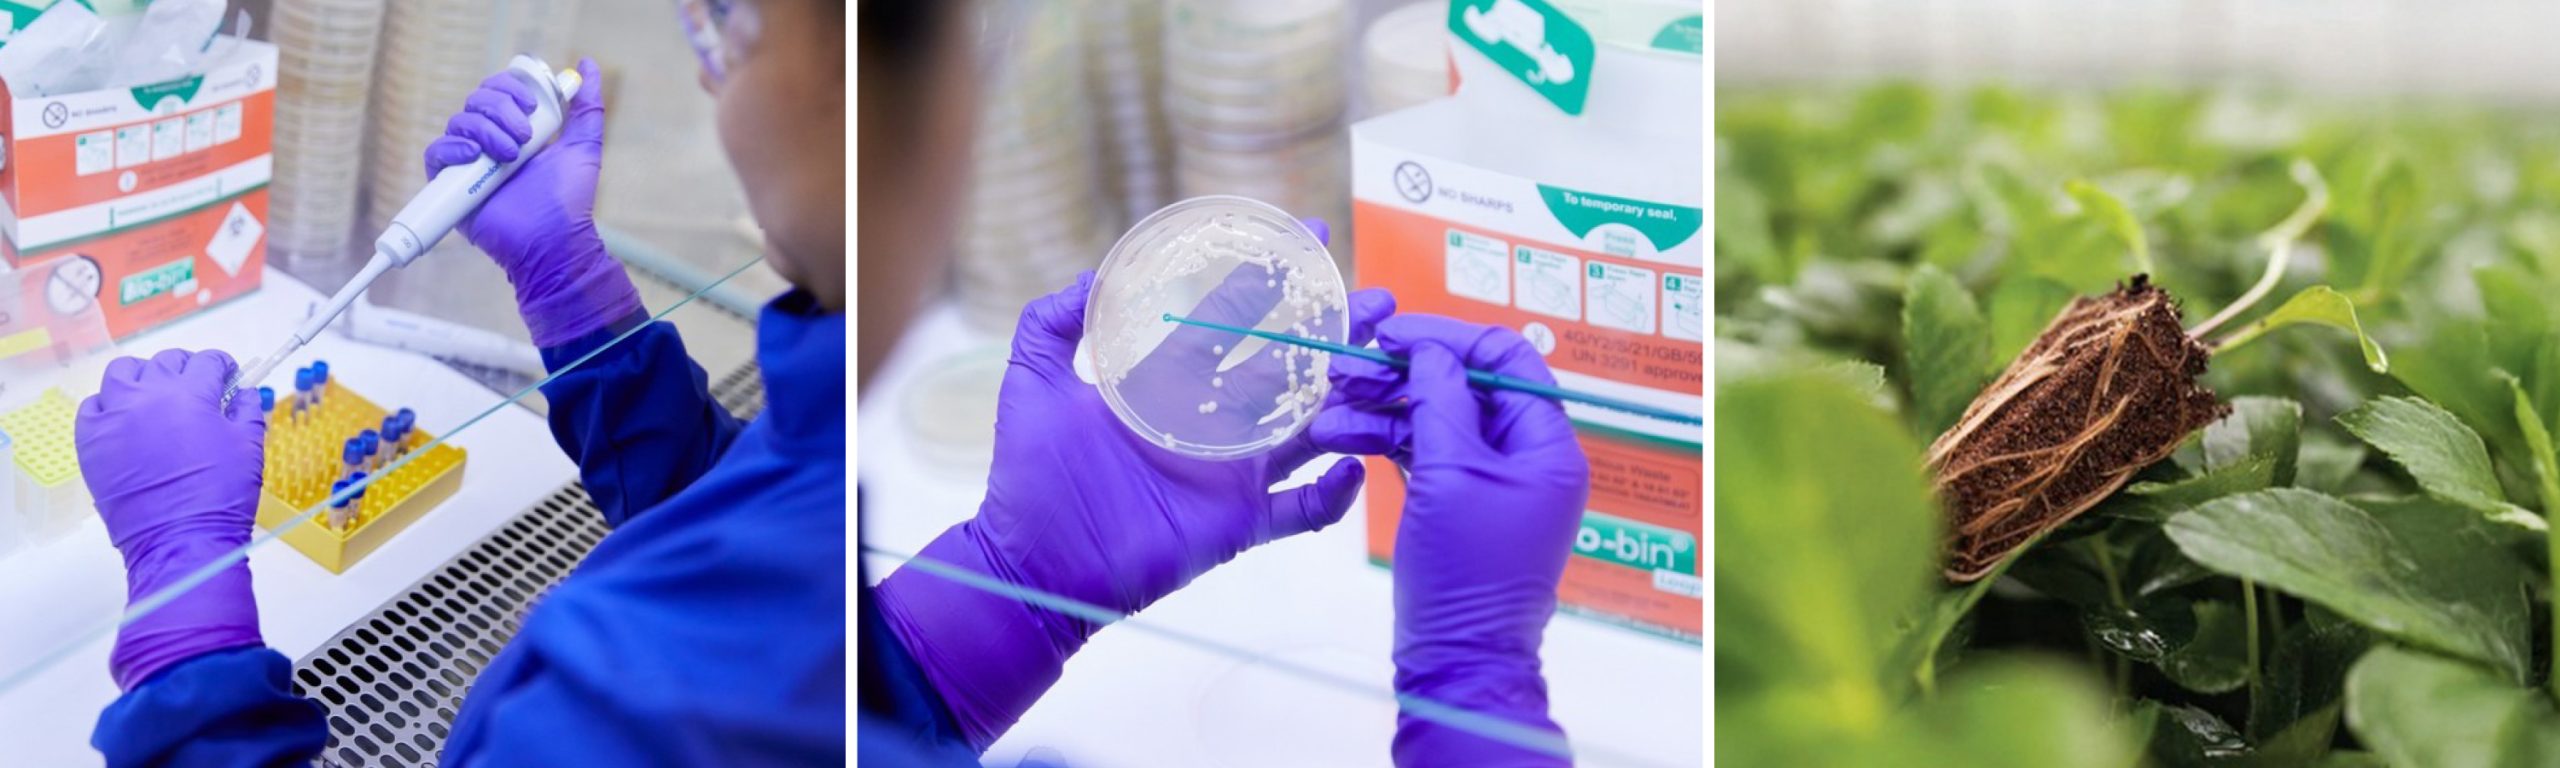

A high-performing substrate must offer the right balance of physical and chemical properties: water retention, aeration, drainage, and nutrient availability. But today’s CEA systems demand more. Jiffy substrates are designed to go further by fostering a dynamic and beneficial plant microbiome that enhances nutrient uptake, strengthens resistance to disease, and improves stress tolerance.
The microbiome in organic substrates like peat, coir, and wood fiber introduces beneficial bacteria and fungi that interact with plant roots. These microbes play key roles in supporting plant development, especially in CEA systems where microbial diversity is often limited. While sterile growing environments may seem ideal, they can actually make crops more vulnerable by removing beneficial microbes and creating an opening for pathogens to take hold. Microbial diversity is essential to creating a balanced ecosystem that protects against disease and supports strong root development.
Managing this microbial balance begins with the selection of high-quality raw materials and careful processing that maintains the biological, physical, and chemical properties of the substrate. Factors such as storage, transportation, and material freshness also contribute to preserving beneficial microbial activity while minimizing the presence of pathogens.
Our collaboration with Concert Bio has shown that beneficial microbes found in natural materials like peat and coco can positively influence plant performance across a range of growing media. These findings reinforce the importance of using substrates that not only support plant nutrition and structure, but also carry a resilient, living microbial community.
Alongside microbiome management, food safety remains a critical pillar of substrate production. Substrates have a direct impact on the crops that reach consumers, which is why Jiffy applies rigorous food safety protocols—from raw material selection to certified processing methods. Our substrates are produced to high safety standards, helping growers reduce contamination risks, meet regulatory requirements, and maintain consumer trust.
By combining microbiome excellence with strong food safety practices, Jiffy substrates help indoor growers achieve consistent results with healthier crops and greater peace of mind.
For more insights, watch our Microbiome Webinar! CLICK HERE